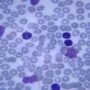
Как лечить уретрит?

Цистит – это заболевание, от которого страдают, в основном, женщины. С проявлением острого цистита сталкивается практически каждая вторая женщина.
Цистит – это заболевание, от которого страдают, в основном, женщины. С проявлением острого цистита сталкивается практически каждая вторая женщина.
Если же после лечения болезнь рецидивирует, то приходится говорить уже о хроническом цистите. Для того чтобы ответить на вопрос, как лечить хронический цистит, нужно понять причины его возникновения.
Развитию хронической формы цистита способствуют факторы, снижающие эффективность действия иммунной системы организма, в том числе, наличие очага хронической инфекции. Различают нисходящий и восходящий путь, по которому инфекция может проникнуть в мочевой пузырь.
В первом случае, бактерии проникают из почек, а во втором – через уретру. При восходящем типе заражения инфекция может проникать в организм во время полового акта. Способствуют развитию цистита наличие ЗППП и дисбактериоз влагалища.
Поэтому для успешного лечения хронического цистита важно выявить и устранить причину его вызывающую. Если возник вопрос, как лечить хронический цистит, для начала нужно пройти полное обследование, включающее исследование на ЗППП, гепатиты все форм, туберкулез, ЦВМ и герпес. Довольно часто инфекции протекают в скрытой форме, не проявляя явных симптомов, и больные не подозревают о наличии у них ЗППП.
Так же больным с хронической формой цистита назначают цитоскопию, данное обследование позволяет оценить состояние стенок мочевого пузыря и определить вид заболевания. Хотя, в большинстве случаев, причиной цистита является какая-либо инфекция, встречаются виды цистита неинфекционной природы.
Серьезным осложнением может стать интерстициальный цистит, в этом случае воспалительный процесс не ограничивается только слизистой мочевого пузыря, а проникает в мышечную стенку. Вылечить цистит в данной форме консервативными методами практически невозможно, хотя иногда на фоне приема антибиотиков и возникает улучшение состояния.
Так же, осложнением хронического цистита может стать воспаление почек или пиелонефрит. При возникновении двухстороннего пиелонефрита заболевание становится опасным для жизни больного.
Чтобы не допустить развития осложнений, требуется своевременно пройти нужные обследования и начать курс лечения. Ни при каких обстоятельствах нельзя отказываться от приема лекарств, если симптомы заболевания сняты. Нужно довести курс до конца, только тогда можно надеяться, что рецидивов больше не будет.